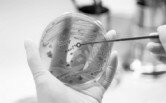

Госдума защитит пассажиров от овербукинга

Фото TripToDream
18.09.2017 | 23:32
Авиакомпании, допускающие продажу большего количества билетов, чем мест на борту (практика овербукинга, которая используется в ряде стран едва ли не повсеместно), будут штрафоваться в десятикратном размере стоимости билета. Законопроект рассматривают депутаты ГД ФС РФ.
Соответствующие поправки внесены зампредседателем парламентского комитета по энергетике, депутатом от «Справедливой России» Игорем Ананских. По его мнению, овербукинг – это нарушение договора между авиакомпанией и пассажирами: сначала перевозчики продают больше билетов, чем мест в самолете, из расчета, что не все пассажиры полетят, а если в аэропорт приезжают все, то кому-то приходится лететь следующим рейсом либо довольствоваться возвратом денег.
Согласно мировой статистике, шанс «попасть под овербукинг» составляет примерно 0,5-1%. Овербукинг считается одним из инструментов управления доходами и узаконен на Западе. В России он пока не регламентируется ничем, кроме правил самих авиакомпаний. «Перевозчики и пускаются на ухищрение: продают дополнительные билеты, чтобы заработать побольше денег», — говорит депутат Ананских. Многие пассажиры опаздывают на деловые встречи, перевозчики портят им отпуск, а наказать авиакомпании нельзя: запрет на овербукинг не прописан ни в Воздушном кодексе, ни в федеральных авиационных правилах.
У авиакомпаний свой взгляд на ситуацию. Они тоже хотят принятия федерального закона, но совершенно обратного, который бы разрешал овербукинг как антикризисную меру. Лоббисты перевозчиков указывают на то, что заранее осведомленный о сверхлимитной продаже билетов пассажир будет мотивирован не опаздывать, садиться в самолет трезвым и четко исполнять все правила. В 2015 году через Минтранс автоперевозчики продвигали законопроект, допускающий одностороннее изменение договора авиакомпанией, если нет возможности предоставить пассажиру место на рейсе согласно билету. Но этот законопроект даже не дошел до парламентского обсуждения. Сейчас все споры между пассажирами и авиакомпаниями разрешает суд. Представители «Аэрофлота» говорят (их мнения приводят СМИ), что, хотя специального «карательного» закона об овербукинге в России нет, через суд пассажир может добиться приравнивания такой практики к мошенничеству. В компании предлагают внести поправки в законодательство и считать мошенничеством только те случаи, когда перевозчик не предупреждает клиента о перебронировании и не предлагает ему никакой компенсации.
Овербукинг разрешен документами Международной ассоциации воздушного транспорта, которая объединяет крупнейших перевозчиков мира. В Евросоюзе и США он является законной практикой и регулируется с помощью ряда ограничений. К примеру, если пассажир из-за перебронирования не может попасть на круизный теплоход, то он должен получить обратно всю стоимость круиза. При этом за ним остается право на компенсацию морального ущерба за испорченный отпуск в судебном порядке. В таких случаях овербукинг применять авиакомпаниям просто невыгодно. В США персонал авиакомпании сначала ищет добровольцев, которые согласны полететь другим рейсом за компенсацию: деньги или ваучер на другой перелет. Если добровольцев нет, то выискиваются «жертвы овербукинга». Из «группы риска» сперва исключаются те, кто купил дорогие билеты, затем те, кто раньше зарегистрировался на рейс. В Евросоюзе овербукингу также не подлежат люди с ограниченными возможностями и их сопровождающие. В странах ЕС компенсации за принудительное перебронирование могут в четыре раза превышать стоимость билета.